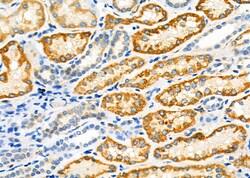
Invitrogen&trade;&nbsp;PIK3IP1 Polyclonal Antibody

missing translation for 'onlineSavingsMsg'
Learn More
Learn More
Invitrogen™ PIK3IP1 Polyclonal Antibody
Rabbit Polyclonal Antibody
Supplier: Invitrogen™ PA5100172
Description
Antibody detects endogenous levels of total PIK3IP1.
The exact function of PIK3IP1 remains unknown.Specifications
| PIK3IP1 | |
| Polyclonal | |
| Unconjugated | |
| Pik3ip1 | |
| 1500004A08Rik; 5830455E04Rik; calcineurin-regulated kringle domain protein; calcineurin-regulated kringle domain-containing protein; Crkd; HGFL; HGFL protein; hHGFL(S); Kringle domain-containing protein HGFL; phosphoinositide-3-kinase interacting protein 1; phosphoinositide-3-kinase-interacting protein 1; Pik3ip1; RGD1311203; zgc:66482 | |
| Rabbit | |
| Affinity chromatography | |
| RUO | |
| 113791, 216505, 305472 | |
| -20°C | |
| Liquid |
| Immunohistochemistry (Paraffin), Western Blot, Immunocytochemistry | |
| 1 mg/mL | |
| PBS with 50% glycerol and 0.02% sodium azide; pH 7.4 | |
| Q56A20, Q7TMJ8, Q96FE7 | |
| Pik3ip1 | |
| A synthesized peptide derived from human PIK3IP1(Accession Q96FE7), corresponding to amino acid residues L2-A52. | |
| 100 μL | |
| Primary | |
| Human, Mouse, Rat | |
| Antibody | |
| IgG |